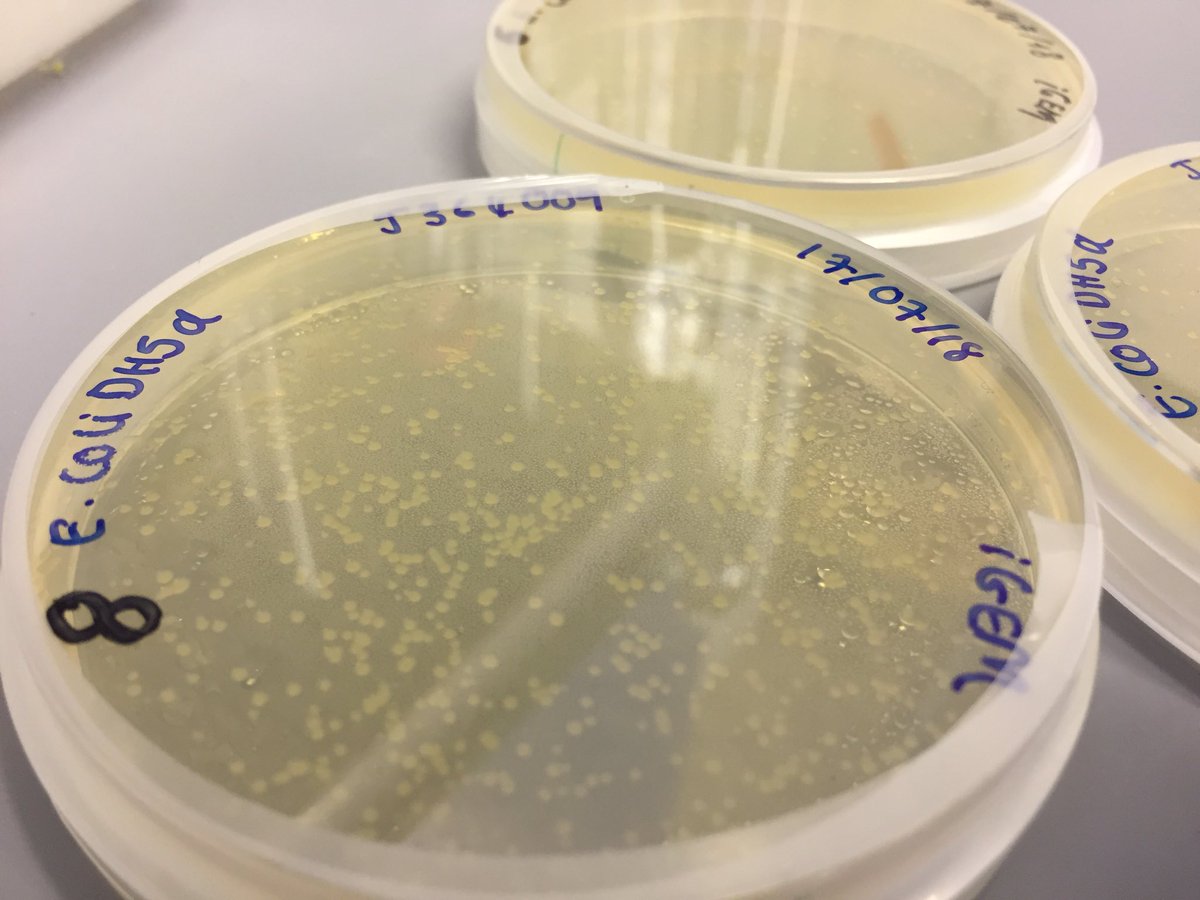
kcligem's tweet image. A sneak peak into how our bacteria are thriving ! 👀 #InterLab #iGEM #E.coli
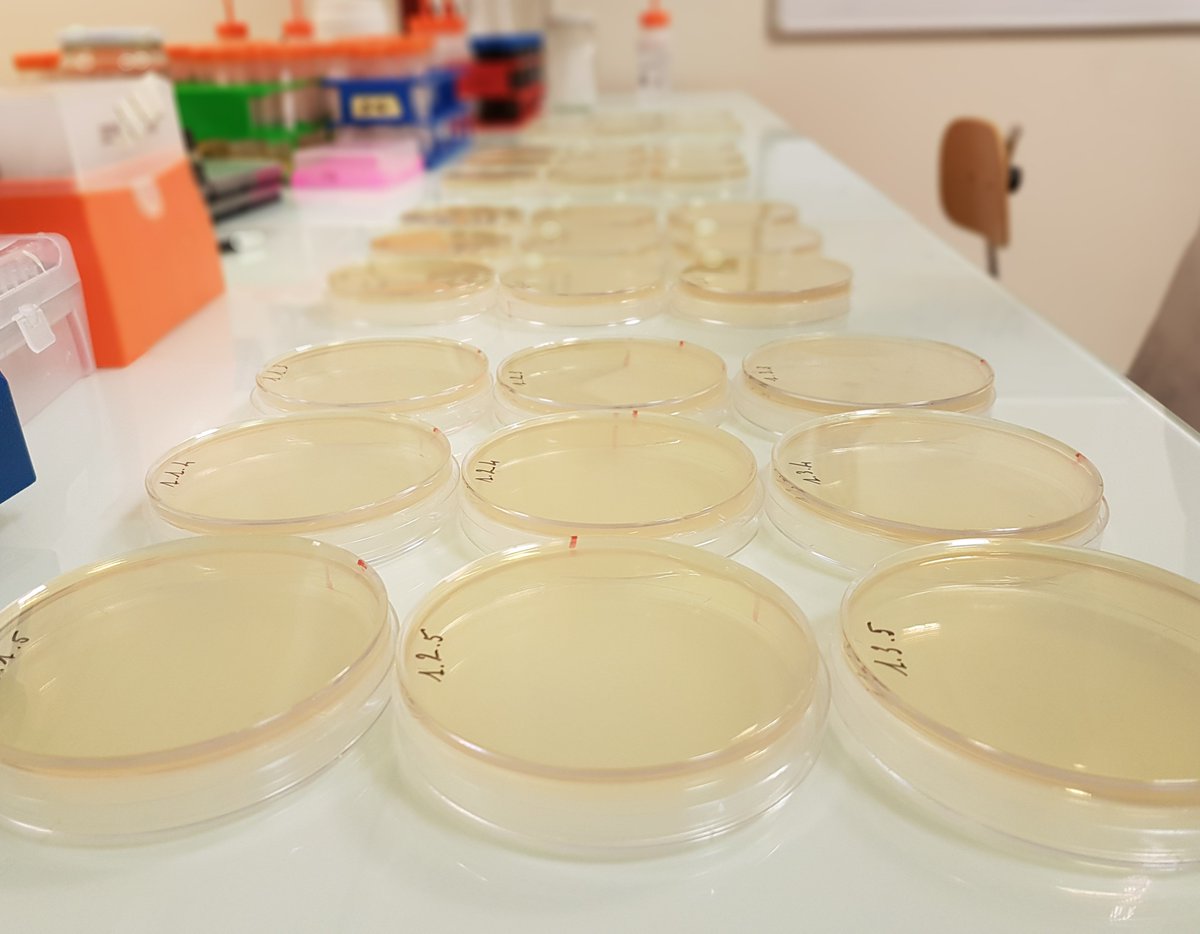
iGEM_Mtp's tweet image. Today was the last #Interlab day ! 
It was the end of a good experience that permitted us to learn more about our host lab ! 
#iGEM #iGEM2018
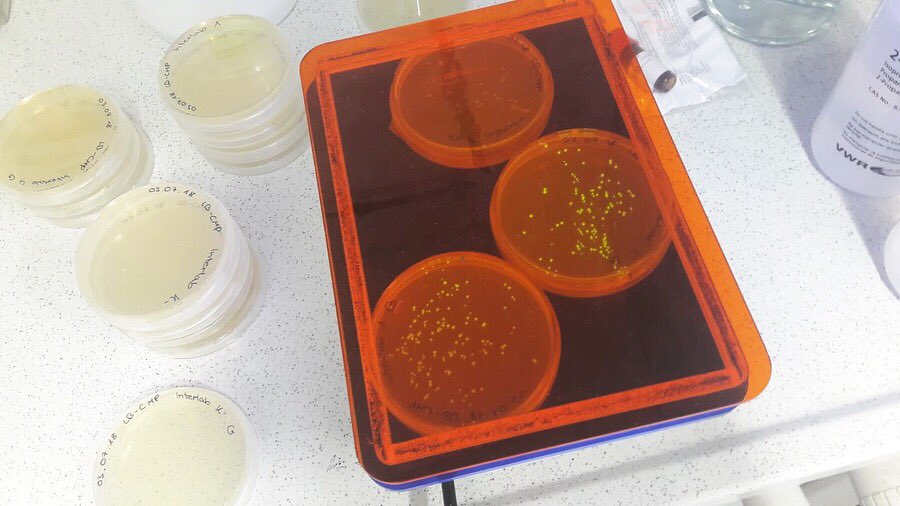
CompuGene_Lab's tweet image. Interlab done ✅  #igemtuda #igem2018 #interlab #thanksjenny #thankseli

#interlab search results

Estas 2 semanas serán de verdadera candela, todos a cuidarse amigos, nada de besos y abrazos a esos vaciles 😂😷, porque acabo de pasar por #Interlab y está reventando. #Guayaquil

Ogni cosa bella nella vita ha un inizio ma anche una fine! Grazie ai miei colleghi di #Sebia ed #Interlab per questi 9 anni meravigliosi

We are very grateful with @NEBiolabs for the support we are given. This will help us a lot in our experimentation and in #interlab! 🙌🏻 ¡Estamos muy emocionados! #iGEM #sponsorship #igem2018 #summertime #welovescience #sciencearoundtheworld #scienceexperiment

Talking about Measurement at #iGEM and the results of the #InterLab Jake Beal @Jacob__Beal #GiantJamboree

“Queremos que nuestras empresas sean más competitivas, que sigan creciendo y proyectándose. Por esto es importante esta alianza entre la academia y el sector empresarial. La invitación es para que nuestros empresarios se vinculen a #Interlab” Pilar Contreras, pdte ejecutiva.
La cadena de laboratorios #Interlab ya cuenta con pruebas de genética molecular que permiten detectar variantes patogénicas en el ADN para conocer si una persona tiene predisposición a desarrollar cáncer. Estos exámenes antes se derivaban al exterior▶️ bit.ly/41dT4SU

Today was the last #Interlab day ! It was the end of a good experience that permitted us to learn more about our host lab ! #iGEM #iGEM2018
#iGEM teams, #InterLab study data is due today! Data sheets and online forms (parts I-IV) should be submitted by 11:59PM EDT! 2018.igem.org/Measurement/In…

The face you make when you've spent 12hrs in the lab. Yesterday was #interlab day ! #iGEM2018 #iGEM #vagineering

Cintia Moschino of Interlab shares her perspective on driving innovation and strategic growth in Mexico’s healthcare sector. Full interview on Mexico Business News. #HealthcareInnovation #Interlab #MexicoBusinessNews #HealthSector #PharmaInnovation mexicobusiness.news/health/news/ex…
Dołącz do bezpłatnych warsztatów online #interlab+ 🧑💻🌍 i rozwiń swoje kompetencje międzykulturowe! 📅 Kiedy? 16 października lub 18 grudnia (godz. 9:00–15:00) 📝 Zapisy do 10. września 👥 Maks. 20 osób w grupie 📩 Formularz zgłoszeniowy i szczegóły 👉 tiny.pl/s5bydmnj

🌍 Zapraszamy wszystkich Studentów i Pracowników Wyższej Szkoły Bezpieczeństwa w Poznaniu na warsztaty międzykulturowe #INTERLAB+! 🎉 ‼️ Liczba miejsc ograniczona – tylko 20 osób! Decyduje kolejność zgłoszeń. więcej szczegółów: tiny.pl/8mgg3q0v #WSB #StudiujWSB

Entrevista: - Dr. Jorge Macías Director Médico de Interlab - Tema: Importancia de los exámenes Preventivos. Programa: Pluri Noticias Ec 03/07/2025 / Unp Guayas / UNP-G.tv Lcdo. Boris Asqui Moreira y Lcda. Fati Del Rocío Castro Torres. #Interlab #doctor
#Interlab inaugura su nueva sede principal en #Guayaquil ow.ly/tUqx50W857M
1983 yılından bu yana laboratuvar malzemeleri ve kimyasallar alanında güçlü bir lider olarak kaliteli ve güvenilir ürünler sunan İnterlab, dijital dönüşüm yolculuğunda önemli bir adım atarak, CoralReef MES çözümümüzü tercih etti. #iletisimyazilim #interlab #işbirliği

Te mostramos el caso de nuestro cliente #Interlab, uno de los principales laboratorios clínicos del país, donde implementamos soluciones avanzadas de #ComunicacionesUnificadas. 📲 Con tecnologías de @SangomaES y @OMniLeads_net llevamos su atención al cliente al siguiente nivel.👏🏻
En sintonía con nuestro lema: “Aprender Haciendo”. ¡Gracias por apoyar el desarrollo académico y científico en la ENCA! #ENCA #INTERLAB #Donación

Este valioso aporte refuerza los insumos del Laboratorio de Análisis de Suelo, contribuyendo directamente a la formación práctica de nuestros estudiantes... #ENCA #INTERLAB #Donación

La Escuela Nacional Central de Agricultura (ENCA) expresa su agradecimiento a la Licda. Suyupa Aguilera y a INTERLAB por la generosa donación de 31 productos reactivos. #ENCA #INTERLAB #Donación


En niveles altos, el plomo en el cuerpo ocasiona daños permanentes en el cerebro y el sistema nervioso. Estos daños pueden provocar convulsiones, pérdida del control muscular y coma. La Dra. Vicenta Cevallos, Subdirectora Técnica de #INTERLAB nos habló de este tema.
La falta de etica de ciertos colegas, en la que cierta empresa establecio un modus operandi..... #interlab
Te lo explico Paul La compañía tiene como accionistas cientos de médicos (revisa la web de la Super de Cias). Esos accionistas tienen un código en cada orden de laboratorio. Ganan por partida doble: la comisión por enviar los exámenes y las utilidades como accionistas. Negocio…
REFORMA TRIBUTARIA. señor @DanielNoboaOk xq no le cobran impuestos a los doctores privados, a ellos nadie les controla tarifas, hacen negociados con #interlab perjudicando a los pacientes con exámenes innecesarios
Something went wrong.
Something went wrong.
United States Trends
- 1. #Fivepillarstoken 1,415 posts
- 2. Cyber Monday 33.7K posts
- 3. #IDontWantToOverreactBUT N/A
- 4. #MondayMotivation 7,748 posts
- 5. TOP CALL 11K posts
- 6. Good Monday 38.5K posts
- 7. Alina Habba 11.5K posts
- 8. Mainz Biomed N/A
- 9. Check Analyze N/A
- 10. Token Signal 2,714 posts
- 11. Victory Monday 1,101 posts
- 12. #GivingTuesday 1,900 posts
- 13. #MondayVibes 3,283 posts
- 14. Market Focus 2,411 posts
- 15. New Month 404K posts
- 16. JUST ANNOUNCED 18.6K posts
- 17. Clarie 2,760 posts
- 18. Rosa Parks 3,252 posts
- 19. John Denver 1,772 posts
- 20. White House Christmas 7,437 posts